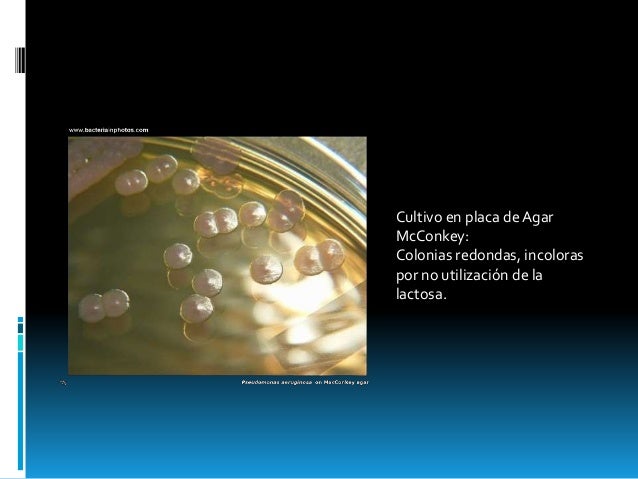
Pseudomona aeruginosa

If you are searching about Pseudomonas - EcuRed you've came to the right web. We have 9 Images about Pseudomonas - EcuRed like U4: Bacterias. Conceptos generales. Bacterias transmitidas por, Scientists Turn Bacteria Into DNA Tape Recorders | IFLScience and also Un medicamento común en la lucha contra bacterias resistentes | Dciencia. Here you go:
Pseudomonas - EcuRed
 www.ecured.cu
www.ecured.cu pseudomonas veterinaria bakterien aeruginosa microbiología mesenteroides leuconostoc ecured bakteri enfermedades schmarotzer biologi toksin produksi penyebab makanan
Significado De Bacteria
 elsignificadode.com
elsignificadode.com definición nomenclatura
Scientists Turn Bacteria Into DNA Tape Recorders | IFLScience
bacteria dna recorders iflscience scientists tape turn
Brucellas (expo. Microbiologia)
 es.slideshare.net
es.slideshare.net microbiologia bacterias
U4: Bacterias. Conceptos Generales. Bacterias Transmitidas Por
 cidta.usal.es
cidta.usal.es Un Medicamento Común En La Lucha Contra Bacterias Resistentes | Dciencia
GLI ARGOMENTI SPAZIANO: BACILLUS THURINGIENSIS - Batterio Aerobio
 gliargomentispaziano.blogspot.com
gliargomentispaziano.blogspot.com bacillus thuringiensis bacterias israelensis bt microorganismos imprimir conservar bacteria batterio aerobio vive terreno insectos
Microbiologia E Imunologia On-line - CULTURA E IDENTIFICAÇÃO DE AGENTES
 microbiologybook.org
microbiologybook.org Pseudomona Aeruginosa
es.slideshare.net
es.slideshare.net aeruginosa pseudomona colonias cultivo
Aeruginosa pseudomona colonias cultivo. Bacteria dna recorders iflscience scientists tape turn. Bacillus thuringiensis bacterias israelensis bt microorganismos imprimir conservar bacteria batterio aerobio vive terreno insectos